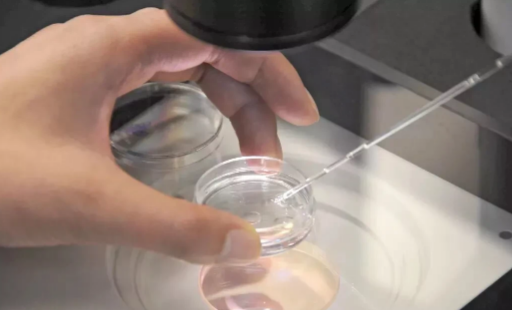

随着辅助生殖技术的不断进步,越来越多的家庭选择在长沙寻求供卵试管的服务,以实现生育梦想。2025年,长沙地区在这一领域迎来了新的政策调整与费用优化,为求子家庭提供了更多便利与保障。本文将为您详细介绍长沙供卵试管费用相关信息,助您轻松踏上圆梦之旅。
最新政策动态
2025年,长沙市积极响应国家鼓励生育政策,对供卵试管等辅助生殖技术实施了一系列利好措施。包括但不限于:
1.扩大医保覆盖范围:部分检查与治疗费用纳入医保报销范畴,减轻家庭经济负担。
2.优化审批流程:简化申请手续,缩短等待时间,提高服务效率。
3.加强监管与服务质量:提升医疗机构资质审核标准,确保服务安全与有效性。
费用明细概览
| 费用项目 | 费用估算(元) | 备注 |
|---|---|---|
| 初步检查费 | 2000-3000 | 包括夫妻双方基础体检 |
| 供卵者筛选费 | 5000-8000 | 涵盖供卵者健康检查与匹配费用 |
| 试管手术费 | 30000-50000 | 包括取卵、受精、胚胎培养及移植 |
| 药品费用 | 10000-20000 | 促排卵药物及其他辅助治疗药物 |
| 冷冻保存费(可选) | 3000-5000 | 胚胎冷冻及后续管理费用 |
| 后续监测与保胎费 | 2000-5000 | 成功移植后的监测与必要保胎治疗 |
注:以上费用仅供参考,具体金额需根据个人情况、医院政策及医保报销比例调整。

申请流程指南
1.咨询与预约:通过电话或网络平台咨询,预约初次就诊。
2.全面检查:夫妻双方进行必要的身体检查,评估生育条件。
3.供卵者匹配:根据需求选择合适的供卵者,完成法律与伦理审核。
4.治疗方案制定:医生根据检查结果制定个性化治疗方案。
5.手术与后续治疗:按照计划进行试管手术及必要的后续治疗。
6.跟踪随访:成功移植后,定期进行监测,确保母婴健康。
心理支持与咨询服务
面对辅助生殖过程中的压力与挑战,长沙多家医疗机构提供专业的心理咨询服务,帮助夫妇缓解焦虑、增强信心。服务包括但不限于一对一咨询、团体辅导、在线心理课程等,旨在全方位支持求子家庭的心理健康。
后续服务与保障
成功怀孕后,长沙的医疗机构还提供一系列后续服务,包括孕期管理、产前诊断、分娩计划及新生儿护理指导等,确保母婴安全与健康。同时,对于未成功者,提供再次尝试的优惠方案或转介其他生育辅助方案,给予持续关怀与支持。

总结:2025年,长沙供卵试管领域在政策、费用、流程、心理支持及后续服务上的全面升级,为渴望拥有自己孩子的家庭铺设了一条更加顺畅、温馨的道路。让我们携手并进,在这条希望的旅程中,共同迎接新生命的到来。愿每一对求子夫妇都能在这片充满爱的土地上,收获属于自己的幸福与喜悦。